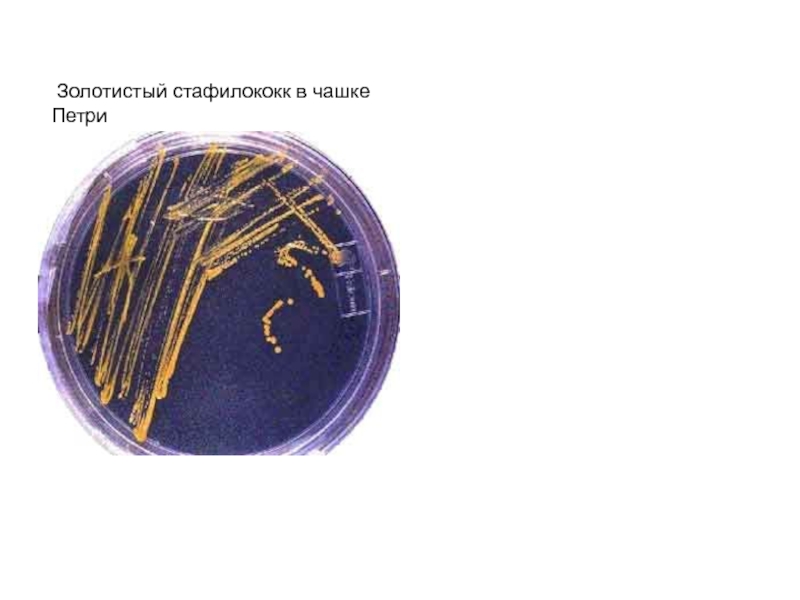

Слайд 2 ГРАМПОЛОЖИТЕЛЬНЫЕ КОККИ
Стафилококки:
Staphylococcus species -Гнойно-воспалительные заболевания
Стрептококки
Streptococcus
species - Гнойно-воспалительные заболевания, скарлатина, рожа
Streptococcus pneumoniae - Гнойно-воспалительные заболевания
Энтерококки- Enterococcus species
Микрококки- Micrococcus species
Пептококки-Peptococcus species
Пептострептококки-Peptostreptococcusspecies
Слайд 3
ГРАМОТРИЦАТЕЛЬНЫЕ КОККИ
Гонококки- Neisseria gonorhoeae - Гонорея
Менингококки- Neisseria meningitidis
-Менингококковая инфекция
Моракселлы-
Подроды Moraxella, Branhamella -
Гнойно-воспалительные заболевания
Вейллонеллы -Veillonella
Слайд 4Стафилококки (род Staphylococcus) (греч. staphyle - виноградная гроздь) - грамположительные
круглые кокки диаметром 1мкм, располагающиеся в чистой культуре в виде скоплений,
напоминающих виноградные гроздья, а в патологическом материале - небольшими скоплениями кокков. Неподвижны. Красятся всеми анилиновыми красками. Факультативные анаэробы. Разделяются на виды Staphylococcus aureus (наиболее патогенный для человека),
S. epidermidis, S. saprophyticus и др.
Колонии S.aureus, растущие на кровяном
агаре Видны зоны гемолиза вокруг Мазок чистой культуры S.aureus колоний
Окраска по Граму
Слайд 5Факторы вирулентности Staphylococcus aureus
Слайд 6Факторы вирулентности Staphylococcus aureus
Токсины
Альфа-, бета-, гамма-, дельта-токсины, лейкоцидин-Токсичны для многих
клеток, включая лейкоциты, эритроциты, макрофаги и фибробласты
Альфа-токсин - пример
порообразующего токсина.
Эксфолиативный токсин- Вызывает синдром "ошпаренной кожи", разрушая межклеточные контакты - десмосомы в гранулярном слое эпидермиса. Суперантиген (поликлональная активация Т-лимфоцитов, стимуляция продукции цитокинов)
Токсин синдрома токсического шока -Нейротропные, вазотропные эффекты. Суперантиген.
Энтеротоксины (А - Е) - Нейротропные эффекты, действие на энтероциты (стафилококковая пищевая интоксикация).Суперантиген
Слайд 7Факторы вирулентности Staphylococcus aureus
ФЕРМЕНТЫ
Плазмокоагулаза (коагулаза)-Конверсия фибриногена в фибрин, препятствующего контакту
с фагоцитами ("псевдокапсула")
Гиалуронидаза- Разрушение соединительной ткани
Липазы - Гидролиз липидов
Стафилокиназа
(фибринолизин) -Разрушение фибриновых сгустков
Дезоксирибонуклеаза -Расщепление ДНК, разжижение гноя
ДРУГИЕ КОМПОНЕНТЫ:
Каратиноидные пигменты- Инактивация бактерицидных форм кислородаУстойчивость к NaCl, жирным кислотам. Размножение в потовых и сальных железах
Слайд 8Симптомы и течение.
Инкубационный период продолжается несколько дней.
Клинические проявления стафилококковых
болезней многообразны. Их можно разделить на следующие группы:
Заболевания кожи и
подкожной клетчатки (фурункулы, пиодермии, сикоз, абсцессы, флегмоны).
Ожогоподобный кожный синдром.
Поражение костей и суставов (остеомиелиты, артриты).
Синдром токсического шока.
Стафилококковая ангина.
Стафилококковый эндокардит.
Пневмонии и плевриты.
Острые стафилококковые энтериты и энтероколиты.
Отравление стафилококковым энтеротоксином.
Стафилококковый менингит и абсцесс мозга.
Стафилококковые заболевания мочевых путей.
Стафилококковый сепсис.
Слайд 9Лабораторная диагностика стафилококков.
Цель лабораторной диагностики- идентификация стафилококков от других микрококков
и определение их видовой принадлежности.
Биоптат- кровь, гной, слизь из зева,
носа, отделяемое ран, мокрота ( при пневмонии), испражнения ( при колите), промывные воды желудка, пищевые продукты ( при отравлениях).
Посев материала на- кровяной агар (гемолиз), молочно-желточно-солевой агар ( NaCl кгнетает рост других микроорганизмов).
Идентификация выделенной культуры – определение признаков и факторов патогенности ( сбраживание маннита, золотистый или белый пигмент, гемолиз, плазмокоагулаза).
Определение чувствительности к антибиотикам.
Слайд 10 Золотистый стафилококк в чашке Петри
Слайд 12Стрептококки - кокки неправильной круглой формы, располагающиеся в виде цепочек
или попарно, размеры 0,5-2,0 мкм. Неподвижны, спор не имеют, некоторые
образуют капсулы. Грамположительные, факультативные анаэробы
Стрептококк в гное. Окраска по Граму Strepococcus pyogenes. Чистая
культура Окраска метиленовым
синим
Слайд 13Факторы вирулентности стрептококков.
Капсула - антифагоцитарная активность
M-белок - антифагоцитарная активность, разрушает C3b-компонент
комплемента.
F-протеин опосредует прикрепление стрептококка к эпителиальным клеткам
Пирогенные экзотоксины (эритрогенины) -обладают пирогенным
эффектом, усиливают гиперчувстиветельность замедленного типа и чувствительность к эндотоксину, иммуносупрессивный эффект на функции B-лимфоцитов, появление сыпи.
стрептолизин S - разрушает лейкоциты, тромбоциты и эритроциты; стимулирует освобождение лизосомальных ферментов; не иммуногенен.
Стрептолизин О - разрушает лейкоциты, тромбоциты и эритроциты; стимулирует освобождение лизосомальных ферментов; иммуногенен
Стрептокиназа - разрушает кровяные сгустки (тромбы), облегчает распространение бактерий в тканях
ДНК-аза- деполимеризует внеклеточную ДНК в гное
Слайд 14Виды стрептококков
Streptococcus pyogenes (прежнее название Streptococcus haemolyticus) — бета-гемолитические стрептококки
группы А. Диаметр клеток — 0,6—1 мкм, многие штаммы образуют
капсулу. Капсульные штаммы растут в виде слизистых колоний, при стоянии переходящих в матовые; бескапсульные штаммы формируют блестящие глянцевидные колонии. Не растут при 10 и 45°, в бульоне с 6,5 % хлорида натрия, при рН 9,6, в молоке с 0,1 % метиленового синего. Ферментируют глюкозу, лактозу, сахарозу, салицин, трегалозу, не ферментируют инулин, сорбит, глицерин, гиппурат натрия. Большинство штаммов продуцируют стрептолизины, стрептокиназу, стрептодорназу, некоторые — эритрогенный токсин. Обитают у человека в глотке в норме и могут вызывать различные заболевания;
Слайд 15
2) Streptococcus pneumoniae — объединяют в группу пневмококковых инфекций. Возбудитель
представляет собой кокки с вытянутым полюсом, располагаются попарно или короткими
цепочками, неподвижны, спор не формируют, при обитании в организме образуют капсулу, хемоорганотрофы, факультативные анаэробы. Паразит дыхательных путей человека. Встречается в норме при различных заболеваниях. Вызывает острые пневмонии и бронхит у детей и взрослых;
Слайд 16Виды стрептококков
3—4) Streptococcus faecalis, Streptococcus faecies — стрептококк группы D,
которые обычно объединяются в группу энтерококков, вызывают септические процессы;
5—8) Streptococcus
sanguis, Streptococcus salivarius, Streptococcus mitis, Streptococcus mutans — гемолитические и негемолитические стрептококки различных серогрупп, продуцирующие полисахариды и принимающие участие в образовании зубных бляшек, предполагается их этиологическая роль при кариесе;
9) Streptococcus lactis (переведен в род Lactococcus) — молочнокислый стрептококк, молочнокислая бактерия.
Слайд 17Заболевания, вызываемые стрептококками
Рожистое воспаление
Скарлатина
Гломерулонефрит
Ревматизм
Ангина
Фарингит
Стрептодермия
Пародонтит
Абсцесс
Бронхит
Пневмония
Эндокардит
Лимфаденит
Слайд 20Грамотрицательные кокки
N. gonorrhoeae (гонококки) - грамотрицательные диплококки. Вызывают гонорею -
антропонозную венерическую инфекцию, характеризующуюся гнойным воспалением слизистых оболочек, чаще мочеполовой
системы. Заболевания: уретрит, цервицит, сальпингит, проктит, бактериемия, артрит, конъюнктивит (бленорея), фарингит. Реже вызывает воспаление глотки и прямой кишки. Источник инфекции - больной человек. Возбудитель передается половым путем, реже через предметы обихода (белье, полотенце, мочалка). При бленнорее заражение новорожденного происходит через инфицированные родовые пути матери.
Род Neisseria состоит из более чем 10 видов: N.canis, N.cinerea, N.denitrificans, N.elongata, N.flavescens, N.gonorrhoeae, N.lactamica, N.macacae, N.meningitidis, N.mucosa, N.polysaccharea, N.sicca, N.subflava
Слайд 21 Гонококки - грамотрицательные диплококки (от греч. diplo - двойной)
бобовидной формы, располагаются парами, прилегая друг к другу вогнутой стороной
(размером 1,25-1,0 х 0,7-0,8 мкм). Имеют нежную капсулу и пили. В гнойном отделяемом характерно расположение гонококков внутри и вне фагоцитирующих клеток - лейкоцитов (незавершенный фагоцитоз). Аэробы, растут на воздухе, обогащенном СО2.
Чистая культура N.gonorrhoeae.
Окраска по Граму
N.gonorrhoeae. Мазок из гноя. Окраска метиленовым синим
Слайд 22Факторы вирулентности Neisseria gonorrhoeae
пили (белок-пилин-)прикрепление гонококков к эпителию влагалища,
фаллопиевых труб и полости рта.
Капсула- антифагоцитарная активность
протеин I -(Por-пориновый белок)способствует
внутриклеточному выживанию бактерий, препятствуя слиянию лизосом с фагосомой нейтрофилов
протеин II- (Opa - Opacity protein; Opacity - мутность) т.е. протеин мутности опосредует плотное прикрепление к эпителиальным клеткам и инвазию внутрь клеток
протеин III -(Rmp - Reduction -modifiable protein) защищает поверхностные антигены (Por-белок, липоолигосахарид) от бактерицидных антителLOS (Lipooligosaccharide)обладает свойствами эндотоксина
IgA1-протеаза- разрушает IgA1
бета-лактамаза гидролизует бета-лактамное кольцо пенициллинов
Слайд 23Микробиологическая диагностика.
Бактериоскопический метод - окраска двух мазков:
1)
по Граму; 2) 1% водым раствором метиленового синего и 1%
спиртовым раствором эозина.
Бактериологический метод: посев на питательные среды, содержащие нативные белки крови, сыворотки или асцитической жидкости;
используют безасцитные среды (например, среда КДС-1 с гидролизатом казеина, дрожжевым аутолизатом и нативной сывороткой); оптимум роста в атмосфере 10-20% углекислого газа, при рН 7,2-7,4 и температуре 37°С.
Молекулярно-генетический метод ( ПЦР)- тест с ДНК-зондом.
Слайд 24Neisseria meningitidis (менингококки)
Neisseria meningitidis (менингококки) - грамотрицательные диплококки рода
Neisseria; вызывают менингококковую инфекцию, характеризующуюся поражением слизистой оболочки носоглотки, оболочек
головного мозга, септицемией, бактерионосительством.
Человек - единственный природный хозяин менингококков.
Путь передачи - воздушно-капельный.
Необходимо дифференцировать патогенные менингококки от других видов нейссерий (N. sicca и N. mycosa), являющихся комменсалами ротоглотки.
Слайд 25N.meningitidis.
N.meningitidis.
Мазок из спиномозговой жидкости при
эпидемическом чистая культура Цереброспинальном менингите окраска по Граму. Окраска метиленовым синим
Слайд 26N.meningitidis.
Менингококки - мелкие до 1мкм диплококки, располагающиеся в виде пары
кофейных зерен, обращенных вогнутыми поверхностями друг к другу. Неподвижны, грамотрицательны,
спор не образуют, имеют пили, микрокапсулу; капсула непостоянна.
Аэробы. Повышенная концентрация CO2 стимулирует рост менингококков.
По капсульным полисахаридным антигенам менингококки делят на основные серогруппы A, B, C, D и дополнительные X, Y, Z, W-135, 129 и др. (всего 13 серогрупп).
По антигенам клеточной стенки менингококки разделяются на серовары 1, 2, 3 и так далее.
Наиболее частыми возбудителями менингококковых инфекций являются представители серогрупп A, B, C, X, Y и W-135. Внутривидовая идентификация имеет эпидемиологическое значение.
Слайд 27Факторы вирулентности Neisseria meningitidis
эндотоксин -опосредует большинство клинических проявлений
пили (белок-пилин)-
прикрепление менингококков к клеткам человека, главным образом, к эпителию носоглотки,
оболочек мозга. капсула антифагоцитарная активность
IgA-протеазы- расщепление молекулы IgA в шарнирной области, защищающее бактерии от действия антител
Слайд 28Микробиологическая диагностика.
Материал для исследования: цереброспинальная жидкость, слизь из
носоглотки, кровь.
Бактериоскопический метод - окраска мазков по Граму
или метиленовым синим.
Бактериологический метод - выделение чистой культуры на средах с добавлением нормальной лошадиной сыворотки или сыворотки крупного рогатого скота и ее идентификация по биохимической активности, антигенной структуре.
ПЦР-диагностика ( ДНК возбудителя, серогруппа))
Специфическая профилактика. С помощью менингококковой химической полисахаридной вакциной серогрупп А, В, С (в зависимости от циркулирующих штаммов). Весьма перспективна поливалентная менингококковая вакцина с полисахаридами групп A, C, Y и W135
Слайд 29Пневмококки - бактерии рода Streptococcus.
Пневмококки - грамположительные кокки, обычно ланцетовидной
формы, располагающиеся парами (диплококки) или короткими цепочками, размеры 0,5-1,2 мкм.
Неподвижны, образуют полисахаридную капсулу в органах, спор не имеют, факультативные анаэробы.
По антигенным свойствам полисахаридов пневмококки разделяются на 90 сероваров (серотипов).
Колонии S. pneumoniae вызывают альфа-гемолиз на кровяном агаре при аэробном культивировании и бета-гемолиз при культивировании в анаэробных условиях.
Большинство сероваров - нормальные обитатели верхних дыхательных путей; могут вызывать пневмонии, синуситы, отиты, менингиты и другие инфекционные процессы при снижении резистентности макроорганизма
Слайд 30Вейлонеллы
Вейлонеллы (род Veillonella) - грамотрицательные кокковидные бактерии 0,3-0,5 мкм
в диаметре, располагающиеся парами или реже по одиночке, иногда небольшими
скоплениями. Неподвижны. Спор и капсул не образуют. Облигатные анаэробы.
Являются представителями нормальной микрофлоры полости рта, кишечника и верхних дыхательных путей.
Слайд 31Вейлонеллы
Вейлонеллы - грамотрицательные кокковидные бактерии рода Veillonella, который состоит из
7 видов; у человека чаще встречаются V.atypica, V.dispar, V.parvula.
Условно-патогенные бактерии
в ассоциациии с другими микробами, вызывающие гнойно-воспалительные заболевания полости рта, носоглотки, брюшной полости. V.parvula - чистая культура. Окраска по Граму